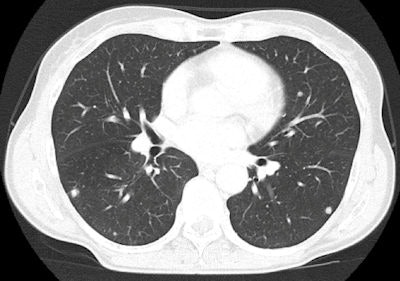

Using social media effectively can aid diagnoses and facilitate closer collaboration among colleagues, and it can also be a powerful educational tool, according to Dr. Lorenzo Faggioni, a radiologist on the advisory board of the Radiology Informatics Section of the Italian Society of Medical Radiology (SIRM).
Radiologists should be aware of the new possibilities offered by social media, according to Dr. Lorenzo Faggioni.
For example, if a radiologist needs help with a case, it is much more practical and efficient to look for a peer-reviewed, targeted article on a recognized educational website, rather than browsing large treatises or general radiology textbooks, he said. The same is true for students and researchers looking up features of a condition or an imaging technique.
Social media can be essential to get information about particular conditions that occur rarely and are hard to find on regular textbooks, in particular, patients with comorbidities and/or distorted anatomy due to surgical interventions, Faggioni added. "I remember one occasion on which [Radiolopolis' app] RadDx Chest was vital for me!" he said.
In addition, online consultation with colleagues or other specialists is much easier and allows for reduced reporting times and case interpretation errors, Faggioni noted. For instance, OsiriX provides open-source software that when combined with iChat on the Mac platform enables users to video chat with colleagues while showing them radiological cases in real-time. This has great implications for collaboration because some hospitals are usually more specialized in certain diseases, while they see other conditions more rarely; this inevitably affects their radiologists' performance. It makes sense to collaborate because "One cannot have the same level of knowledge about everything," he said.
While everybody knows Facebook and Twitter are forms of social media, there are other less obvious applications. He lists the websites of Radiographics, AuntMinnieEurope.com, AuntMinnie.com, Medscape, and Radiolopolis as valuable resources, where radiologists can find reviews on virtually any topic and information on continuing medical education, as well as communicate with others in discussion forums.
Some people may still be getting up to speed when it comes to social media. For them, Faggioni offers these practical tips:
When reporting a case, radiologists should first choose within a range of widely recognized resources, such as the websites of radiological societies and public databases (PubMed, Scirus, Scopus, etc.).
Use traceable, referenced material and also check the literature for similar material to confirm or corroborate your findings. Especially for rare or controversial cases, some radiologists will quote literature references in the final report to support their conclusions.
When asking for consultation, provide all details of your case, including the patient's history and all relevant findings, as well as nonradiological ones.
Make sure not to include information that may breach patient confidentiality, and send anonymous versions of images for telereporting.
Smartphones
Seeming to go hand in hand with social media is smartphones, which also allow for the possibility of diagnosing a patient without a workstation. During a presentation at ECR 2011, Faggioni and colleagues illustrated the potential of the iPhone for evaluating CT colonography (CTC) studies -- they compared the performance of the iPhone with that of an iMac and found, although image reading time was longer with the iPhone, lesion detection rates were comparable.
"These results do not mean that the iPhone can replace the iMac for primary reporting of CTC datasets; however, it might be effectively used for preliminary image reading and to quickly share information with clinicians without the need of a costly standalone workstation," he said. The iPhone may find its way in the emergency department to quickly show the key findings of a 1,000-plus image multislice CT exam to clinicians or surgeons, or as a PACS-integrated extension of electronic patient databases, he added.
"The introduction of larger, more powerful devices (such as the iPad 2) is likely to further expand this kind of application, with some surgeons already using it in the operating room to assist interventions," Faggioni said. For instance, the following images of CT pulmonary embolism and knee MRI, as well as the chest CT image of lung nodules above were exported from an iPad 2. "Diagnosis could have been made on it without the need of a workstation," he said.


In the future, social media could be used to recruit patients for clinical trials, but it's not there yet. At the moment, at Faggioni's hospital, referring physicians directly propose enrollment to patients after Institutional Review Board approval and not through social media. Patient enrollment is governed by very tight regulations that in most countries do not recognize social media as a regular channel for recruitment.
"This is mainly because these laws were made well before the advent of social media, and patient confidentiality and other ethical issues should be 100% granted by the new technologies," he said. "However, I think that in principle, social media could be employed at least to inform patients about the possibility to become involved in clinical trials, if they ask to do so."
Obviously the full uses and effects of social media are still unknown, but in the interim education is important.
"Radiologists should be aware of the new possibilities offered by social media, and I think that radiology residents should learn how to use social media as a part of their core curriculum," he said. "On the other hand, older radiologists should be offered update courses that illustrate how to effectively use social media at work."
Be sure to check out Faggioni's presentation at the upcoming MIR congress.